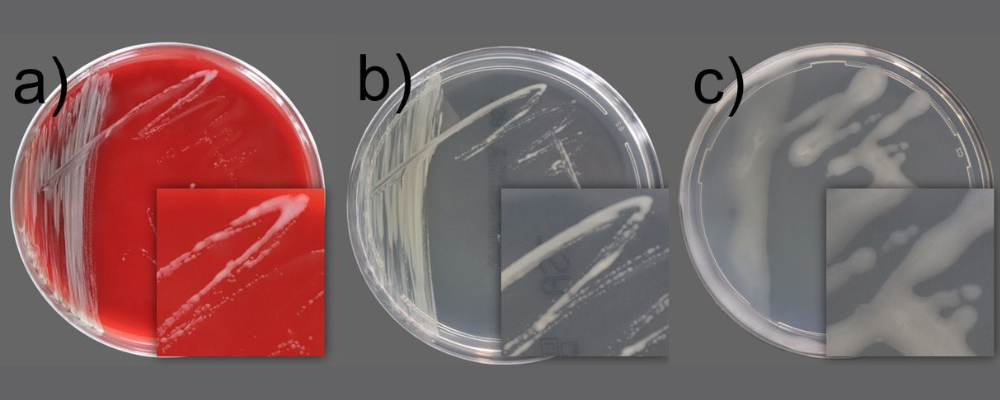

Finde mit KI-Unterstützung konrekte Antworten zu deinen Fragen!
IB Media GmbH
Deine Buchungsoptionen für Cleanroom-Processes und die LOUNGES
Finde mit KI-Unterstützung konrekte Antworten zu deinen Fragen!
Pitzek GMP Consulting GmbH
Inspire GmbH
Geht es um Kontamination im Reinraum, so heißt das primäre Überwachungsziel in der Regel „Partikel“. Das ist nicht verwunderlich, denn Partikel tummeln sich millionenfach in der Luft – pro Kubikmeter wohlgemerkt. Es gibt allerdings eine weitere Form der Verunreinigung, die bei Planung und Realisierung von Reinräumen gern unterschätzt wird: Die molekulare Verunreinigung (Airborne Molecular Contamination AMC). Dabei handelt es sich um gas- oder dampfförmige Substanzen, oft Ausgasungen von Material, Prozesschemikalien oder flüchtige organische Verbindungen. Molekulare Verunreinigungen sind meist wesent-lich kleiner als Partikel und können zu nicht kontrollierbaren chemischen Reaktionen, Korrosion oder Schichtbildung auf Oberflächen führen.
17.04.2026
Die WAREX VALVE GmbH mit Sitz in Senden erweitert ihr Portfolio im Bereich hochwertiger Industriearmaturen um eine speziell für anspruchsvolle Anwendungen entwickelte Prozessabsperrklappe. Die Absperr- und Regelklappe Typ CST DN100 wurde gezielt für den Einsatz in der Prozessluftführung innerhalb pharmazeutischer Anlagen konzipiert und vereint hygienisches Design mit präziser Regeltechnik und maximaler Betriebssicherheit.
17.04.2026
Seit Jahrzehnten gilt das Rühren in der hygienischen Produktion als energieintensiver und wartungsaufwändiger Prozess. Die neue Rührplattform EnSaLine von Alfa Laval wird dies ändern und Herstellern von Lebensmitteln, Molkereiprodukten, Getränken, Pharmazeutika sowie Haushalts- und Körperpflegeprodukten vom ersten Tag an Zeit und Betriebskosten sparen. „Die derzeitigen hygienischen Rührwerke sind in vielen Branchen veraltet, und wir wollten ein wirklich neues und bahnbrechendes Design anbieten, das den Bedarf an müheloser und effizienter Bedienung und Wartung deckt“, sagt Christian Jørgensen, Global Portfolio Manager, Mixing, bei Alfa Laval. „Durch das Feedback unserer Kunden haben wir das Rührwerksdesign von Grund auf neu gedacht und die neue EnSaLine-Reihe entwickelt, die einen neuen und zukunftssicheren Maßstab in der hygienischen Produktion setzt, hohe Effizienz beibehält und gleichzeitig neue Vorteile bietet.“
15.04.2026
Geht es um Kontamination im Reinraum, so heißt das primäre Überwachungsziel in der Regel „Partikel“. Das ist nicht verwunderlich, denn Partikel tummeln sich millionenfach in der Luft – pro Kubikmeter wohlgemerkt. Es gibt allerdings eine weitere Form der Verunreinigung, die bei Planung und Realisierung von Reinräumen gern unterschätzt wird: Die molekulare Verunreinigung (Airborne Molecular Contamination AMC). Dabei handelt es sich um gas- oder dampfförmige Substanzen, oft Ausgasungen von Material, Prozesschemikalien oder flüchtige organische Verbindungen. Molekulare Verunreinigungen sind meist wesent-lich kleiner als Partikel und können zu nicht kontrollierbaren chemischen Reaktionen, Korrosion oder Schichtbildung auf Oberflächen führen.
17.04.2026
Die WAREX VALVE GmbH mit Sitz in Senden erweitert ihr Portfolio im Bereich hochwertiger Industriearmaturen um eine speziell für anspruchsvolle Anwendungen entwickelte Prozessabsperrklappe. Die Absperr- und Regelklappe Typ CST DN100 wurde gezielt für den Einsatz in der Prozessluftführung innerhalb pharmazeutischer Anlagen konzipiert und vereint hygienisches Design mit präziser Regeltechnik und maximaler Betriebssicherheit.
17.04.2026
IB Media GmbH
IB Media GmbH
CCI vK GmbH & Co. KG
Labor LS SE & Co. KG
Bleib informiert mit den neuesten Cleanroom-News in deinem Postfach
Mediathek
Auf den Punkt gebracht
Play Video
16.04.2026
Gast: Dr. Florian Sieder
Auf den Punkt gebracht
Play Video
16.04.2026
Gast: Dr. Florian Sieder
Auf den Punkt gebracht
Play Video
15.04.2026
Gast: Christoph Köth und Patrick Ratheiser
Auf den Punkt gebracht
Play Video
16.04.2026
Gast: Dr. Florian Sieder
Auf den Punkt gebracht
Play Video
16.04.2026
Gast: Dr. Florian Sieder
VIP-Lounge Podcast
2.04.2026
Zu Gast: Dominikus Forsthuber
Moderator/in: Astrid Jacoby
Die heutige Ausgabe der VIP Lounge, mit Dominikus Forsthuber, Geschäftsführer der Allgemeine Bau-Chemie GmbH.
1.04.2026
Zu Gast: Barbara Peither
Moderator/in: Astrid Jacoby
Heute ist Barbara Peither, Vorstand des GMP Verlag in der VIP Lounge zu Gast.
2.04.2026
Zu Gast: Dominikus Forsthuber
Moderator/in: Astrid Jacoby
Die heutige Ausgabe der VIP Lounge, mit Dominikus Forsthuber, Geschäftsführer der Allgemeine Bau-Chemie GmbH.
Reingehört Podcast
3.04.2026
Zu Gast: Matthias Alber
Moderator/in: Susan Weckauf
In dieser Folge von Reingehört ist Matthias Alber, Key Account Manager von Briem zu Gast.
2.04.2026
Zu Gast: Florian Fauerbach
Moderator/in: Susan Weckauf
Heute bei Reingehört ist Florian Fauerbach, Director Advance Industries & Logistics bei PPE Intelligence.
3.04.2026
Zu Gast: Matthias Alber
Moderator/in: Susan Weckauf
In dieser Folge von Reingehört ist Matthias Alber, Key Account Manager von Briem zu Gast.
Vorträge & Aktionen
27.03.2025
Standnummer: E2.4
15:00
Wird in Deutsch präsentiert.
Merkle CAE Solutions GmbH
27.03.2025
Standnummer: H1.2
13:00
Wird in Deutsch präsentiert.
ISPE - International Society for Pharmaceutical Engineering D/A/CH e.V.
Stefan Raabe
25.03.2025
Standnummer: GMP-Forum
13:00
Wird in Deutsch präsentiert.
GMP-Verlag Peither AG
Sabine Paris
27.03.2025
Standnummer: E2.4
15:00
Wird in Deutsch präsentiert.
Merkle CAE Solutions GmbH
27.03.2025
Standnummer: H1.2
13:00
Wird in Deutsch präsentiert.
ISPE - International Society for Pharmaceutical Engineering D/A/CH e.V.
Stefan Raabe
25.03.2025
Standnummer: GMP-Forum
13:00
Wird in Deutsch präsentiert.
GMP-Verlag Peither AG
Sabine Paris
Events
dm-arena Messe Karlsruhe, Messeallee, 1, 76287 Rheinstetten, Deutschland,
24.03.2026
bis
26.03.2026
LOUNGES 2026 Karlsruhe
dm-arena Messe Karlsruhe, Messeallee, 1, 76287 Rheinstetten, Deutschland,
16.03.2027
bis
18.03.2027
LOUNGES 2027 Karlsruhe
Future Faces
ap-systems GmbH
IPS-Integrated Project Services (Germany) GmbH
IPS-Integrated Project Services (Germany) GmbH